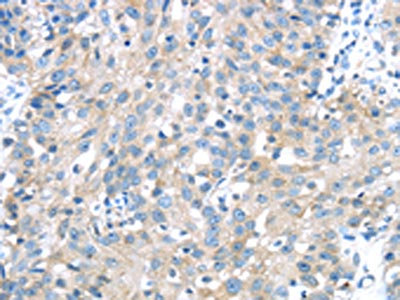

IGFBP3 Antibody
-
中文名稱:IGFBP3兔多克隆抗體
-
貨號:CSB-PA824414
-
規格:¥1100
-
圖片:
-
The image on the left is immunohistochemistry of paraffin-embedded Human thyroid cancer tissue using CSB-PA824414(IGFBP3 Antibody) at dilution 1/40, on the right is treated with synthetic peptide. (Original magnification: ×200)
-
The image on the left is immunohistochemistry of paraffin-embedded Human breast cancer tissue using CSB-PA824414(IGFBP3 Antibody) at dilution 1/40, on the right is treated with synthetic peptide. (Original magnification: ×200)
-
Gel: 8%SDS-PAGE,Lysate: 40 μg,,Primary antibody: CSB-PA824414(IGFBP3 Antibody) at dilution 1/300 dilution,Secondary antibody: Goat anti rabbit IgG at 1/8000 dilution,Exposure time: 1 minute
-
-
其他:
產品詳情
-
Uniprot No.:
-
基因名:
-
別名:Acid stable subunit of the 140 K IGF complex antibody; Binding protein 29 antibody; Binding protein 53 antibody; BP 53 antibody; BP53 antibody; Growth hormone dependent binding protein antibody; IBP 3 antibody; IBP-3 antibody; IBP3 antibody; IBP3_HUMAN antibody; IGF binding protein 3 antibody; IGF-binding protein 3 antibody; IGFBP 3 antibody; IGFBP-3 antibody; IGFBP3 antibody; Insulin Like Growth Factor Binding Protein 3 antibody; Insulin-like growth factor binding protein 3 precursor antibody; Insulin-like growth factor-binding protein 3 antibody
-
宿主:Rabbit
-
反應種屬:Human,Mouse,Rat
-
免疫原:Synthetic peptide of Human IGFBP3
-
免疫原種屬:Homo sapiens (Human)
-
標記方式:Non-conjugated
-
抗體亞型:IgG
-
純化方式:Antigen affinity purification
-
濃度:It differs from different batches. Please contact us to confirm it.
-
保存緩沖液:-20°C, pH7.4 PBS, 0.05% NaN3, 40% Glycerol
-
產品提供形式:Liquid
-
應用范圍:ELISA,WB,IHC
-
推薦稀釋比:
Application Recommended Dilution ELISA 1:2000-1:5000 WB 1:500-1:2000 IHC 1:25-1:100 -
Protocols:
-
儲存條件:Upon receipt, store at -20°C or -80°C. Avoid repeated freeze.
-
貨期:Basically, we can dispatch the products out in 1-3 working days after receiving your orders. Delivery time maybe differs from different purchasing way or location, please kindly consult your local distributors for specific delivery time.
-
用途:For Research Use Only. Not for use in diagnostic or therapeutic procedures.
相關產品
靶點詳情
-
功能:IGF-binding proteins prolong the half-life of the IGFs and have been shown to either inhibit or stimulate the growth promoting effects of the IGFs on cell culture. They alter the interaction of IGFs with their cell surface receptors. Also exhibits IGF-independent antiproliferative and apoptotic effects mediated by its receptor TMEM219/IGFBP-3R. Inhibits the positive effect of humanin on insulin sensitivity. Promotes testicular germ cell apoptosis.
-
基因功能參考文獻:
- In cancerous tissues of colorectal cancer (CRC) patients, the miR197 level was inversely correlated with the expression of IGFBP3, which indicated that miR197 may modulate cell migration and invasion by targeting IGFBP3 in CRC patients. PMID: 30106114
- Together findings presented here recognize an inherent role of MTA1 as a modifier of DNMT3a and IGFBP3 expression, and consequently, the role of MTA1-DNMT3a-IGFBP3 axis in breast cancer progression. PMID: 28393842
- B-Myb is an independent prognostic marker and serves as a potential target in the diagnosis and/or treatment of NSCLC, and that B-Myb functions as a tumor-promoting gene by targeting IGFBP3 in NSCLC cells. PMID: 29772705
- IGFBP-3 up-regulates PI3K/Akt/mTOR signaling pathway and down-regulates autophagy during cell aging. The decrease of IGFBP-3 expression in senescence and cell aging by H2O2 leads to up-regulation of mTOR and p53 signaling pathway, suggesting that IGFBP-3 could play a key role as an aging marker PMID: 29579543
- Low IGFBP-3 serum levels were associated with Pancreatic Cancer. PMID: 28681154
- IGFBP-3 Interacts with the Vitamin D Receptor in Insulin Signaling Associated with Obesity in Visceral Adipose Tissue PMID: 29112142
- IGFBP3, a gene associated with preeclampsia pathophysiology, was validated as a target gene of miR-210 PMID: 28653360
- analysis of IGFBP3-IGF1 correlation with the risk of esophageal carcinoma; the free form of IGFBP3, might be inversely associated with esophageal cancer incidence PMID: 28596684
- Our data indicate that targeting IGFBP-3-dependent signaling pathways through gefitinib-FTY720 co-therapy may be effective in many basal-like breast cancers, and suggest tissue IGFBP-3 and CD44 measurement as potential biomarkers of treatment efficacy. PMID: 28778177
- Laboratory models corroborate intertumor heterogeneity of endocrine response in HGSOC but identify features associated with functional ERalpha and endocrine responsiveness. Assessing ERalpha function (e.g., IGFBP3 expression) in conjunction with H-score may help select patients who would benefit from endocrine therapy. Preclinical data suggest that SERDs might be more effective than tamoxifen PMID: 28073843
- In longitudinal analysis, changes of FGF-21 were not significantly related to changes of height, IGF-1 or IGFBP-3 in obese children. PMID: 26887040
- the concentrations of insulin, IGF-1, IGFBP-3 and their association with prostate size in patients with BPH PMID: 28300542
- We confirmed a previously reported association between circulating IGFBP-3 and diabetes risk in the older adult population PMID: 29040592
- The results of this study, while not clearly supporting associations between these obesity-related biomarkers and renal cell carcinoma risk, are consistent with previously reported findings for adiponectin, and suggest an association with elevated IGFBP-3 among obese individuals PMID: 28484923
- our results reveal a new function of IGFBP2, providing a novel insight into the mechanism of adipogenic differentiation and identifying a potential target mediator for improving adipose tissue engineering based on Wharton's jelly of the umbilical cord (WJCMSCs). PMID: 28859160
- Increased IGFBP3 level as associated with decreased risk of frailty in men. PMID: 28609827
- Functional IGFBP-3 was significantly lower in postmenopausal women than in premenopausal women, for both patients with rheumatoid arthritis and controls. There was a significant decrease in plasma functional IGFBP-3 levels in postmenopausal RA in comparison to healthy premenopausal subjects. PMID: 27775453
- study suggests high-order interactions of the IGFBP-3 rs2854744 AA genotype, BMI>/=24kg/m2, and DISI<9.85 mg/day on increased BC risk, particularly among postmenopausal women PMID: 27631779
- The stratification of individuals by gender revealed that Slovak males carrying IGFBP-3 G alleles (G32G or GG) had marginally increased risk for developing MDD as compared to CC homozygous males (p=0.09). In women, inverse association was observed between SNP rs1042522 and MDD risk (p=0.04 for recessive model). PMID: 27755861
- results indicate that hypoxia suppresses the osteogenic differentiation of mesenchymal stem cells via IGFBP3 up-regulation. PMID: 27563882
- Meta-analysis suggests that for esophageal cancer, the low IGFBP-3 level is associated with high cancer risk, poor prognosis, and unfavorable tumor stage and metastasis. [meta-analysis] PMID: 27978831
- Expression of IL-24 and IGFBP-3 significantly suppressed prostate cancer tumor growth in vivo. PMID: 26323436
- Blood IGFBP3 was lower in Black participants compared to Whites. PMID: 27455178
- The microRNA-125b level promotes invasive ability in p53-mutated cells via PI3K/AKT activation by targeting of insulin-like growth factor-binding protein-3. PMID: 28378642
- High expression of IGFBP3 is associated with metastasis in nasopharyngeal carcinoma. PMID: 27658775
- results indicated that miR-197 targeted IGFBP3 to induce the overgrowth and anti-apoptotic effects of Wilms tumor cells PMID: 27223680
- There is no interaction between IGFBP3 and MTA1 in ESCC, and they are not independent risk factors for esophageal squamous cell carcinoma prognosis. PMID: 27035126
- Insulin-like growth factor binding protein-3 is a new predictor of radiosensitivity on esophageal squamous cell carcinoma PMID: 26670461
- Study showed that IGFBP3 is dramatically induced in pancreatic tumors, and is abundantly produced in pancreatic cancer cells, causing muscle wasting through both impaired myogenesis via, at least, inhibition of IGF/PI3K/AKT signaling. PMID: 26975989
- Insulin-like growth factor-independent insulin-like growth factor binding protein 3 promotes cell migration and lymph node metastasis of oral squamous cell carcinoma cells via integrin beta1 signaling. PMID: 26540630
- endogenous IGFBP-3 is a p53 target that plays a role in breast cancer cell responsiveness to DNA damaging therapy PMID: 26378048
- Data indicate that IGF-binding protein 3 (IGFBP3) and F3 gene expression levels in formalin fixed paraffin embedded (FFPE) prostate cancer tissue would provide an improved survival prediction for prostate cancer patients. PMID: 26731648
- calcineurin in astrocytes was activated by Amyloid beta, leading to IGFBP-3 release. PMID: 26637371
- Circulating levels of IGF-1, IGFBP-3 and their molar ratio were not associated with the risk of occurrence of colorectal adenoma PMID: 26388613
- Independent of obesity, high insulin levels but reduced levels of IGFBP-3 were associated with increased lung cancer risk in current smokers. PMID: 27071409
- IGFBP-3 levels after ischemic stroke may independently predict functional outcome after one year. PMID: 26069074
- -202 A/C IGFBP3 polymorphisms did not show any consistent association with clinical and laboratory features of acromegalic patients even after treatment. PMID: 25552351
- polymorphism in IGFBP-3 rs2854744 A>C might be a potential predictor of esophageal squamous cell carcinoma risk and patient survival PMID: 26349977
- Humanin Peptide Binds to Insulin-Like Growth Factor-Binding Protein 3 (IGFBP3) and Regulates Its Interaction with Importin-beta. PMID: 26216267
- Authors demonstrate that IGFBP3 is a direct TAp73alpha (the p73 isoform that contains the trans-activation domain) target gene and activates the expression of IGFBP3 in actively proliferating cells. PMID: 26063735
- Methylation of IGFBP-3 in colorectal cancer was identified to be significantly associated with risk of recurrence. PMID: 25822686
- Data indicate that IGF binding protein-3 (IGFBP-3) reduced transcription of a variety of integrins, especially integrin beta4. PMID: 25945837
- Serum IGFBP3 was increased in hepatocellular carcinoma patients compared to patients with liver cirrhosis, but lower than in healthy controls. PMID: 26068014
- The current meta-analysis suggests that the IGFBP-3 C2133G polymorphism may confer susceptibility to colorectal cancer. [Meta-analysis] PMID: 25966104
- In women with normal somatotroph function, IGFBP3 levels do not change in the first trimester of pregnancy. PMID: 25179796
- Loss of IGFBP3 expression is associated with Colorectal Cancer. PMID: 25987030
- IGFBP-3 polymorphism is not a cause of delayed infancy-childhood transition in idiopathic short stature children. PMID: 25742716
- The functional IGFBP3 A-202C polymorphism may influence the susceptibility and progression of breast cancer in the Chinese population. PMID: 25960224
- Results suggest that immediately postexercise testosterone and IGFPB-3 responses are significantly increased after endurance training followed by strength training but not after strength training followed by endurance training. PMID: 25028991
- These findings indicate that IGFBP-3 enhances etoposide-induced cell growth inhibition by blocking the NF-kappaB signaling pathway in gastric cancer cells. PMID: 25662950
顯示更多
收起更多
-
亞細胞定位:Secreted.
-
組織特異性:Expressed by most tissues. Present in plasma.
-
數據庫鏈接:
Most popular with customers
-
-
YWHAB Recombinant Monoclonal Antibody
Applications: ELISA, WB, IHC, IF, FC
Species Reactivity: Human, Mouse, Rat
-
Phospho-YAP1 (S127) Recombinant Monoclonal Antibody
Applications: ELISA, WB, IHC
Species Reactivity: Human
-
-
-
-
-